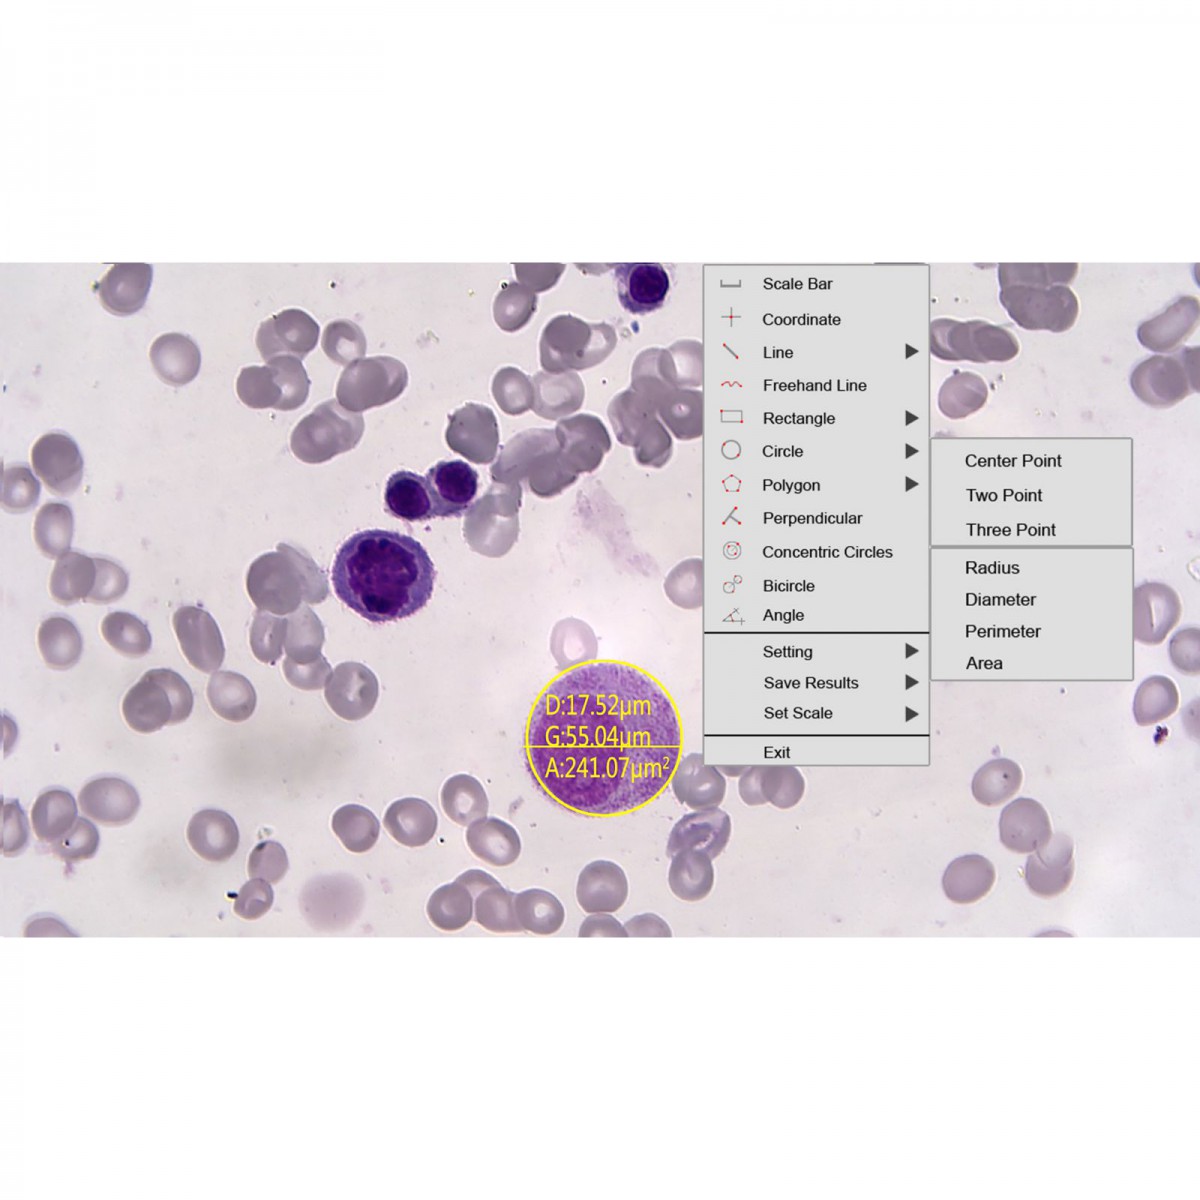
TUCSEN®CMOS 科研相機 Metrics - 商品圖 4

商品圖片僅供參考,選購時請再留意商品規格

商品圖片僅供參考,選購時請再留意商品規格

商品圖片僅供參考,選購時請再留意商品規格
商品圖片僅供參考,選購時請再留意商品規格

商品圖片僅供參考,選購時請再留意商品規格

商品圖片僅供參考,選購時請再留意商品規格

商品圖片僅供參考,選購時請再留意商品規格
TUCSEN®CMOS 科研相機 Metrics
商品包含多種型號及規格,請點選「立即選購規格」挑選
💡 重要通知:
因中東戰爭造成原物料波動影響,若訂單成立後進貨成本發生重大異動,我們將主動聯繫您協商處理。造成不便,敬請見諒。
月結報帳 / 信用卡 / 銀行轉帳
宅配快速到貨,滿 NT$ 999 元即享免運!
商品介紹
1.晶片:Sony CMOS 彩色
2.影像解析度:3264x1836 6MP(靜態) 1920x1080 2MP (動態)
3.感光元件尺寸:1/2.8"
4.畫素:2.9um * 2.9um
5.最高解析度:30 fps@ 1920*1080 (USB/HDMI)
6.支援作業系統:Windows/Mac/Linux
7.輸出介面:USB2.0
8.輸出介面:HDMI 顯示器,SD記憶卡儲存資料、wifi傳輸平板或手機
9.軟體支援8國語言、比例尺、測量工具、自動白平衡、自動曝光時間、影像翻轉、對比、Gama調整
以上圖片及相關資訊由 Tucsen提供。
若有現場安裝、說明或特殊配送需求,歡迎事前與科研市集聯繫。部分商品因供應條件限制,可能無法提供相關服務,敬請見諒。










